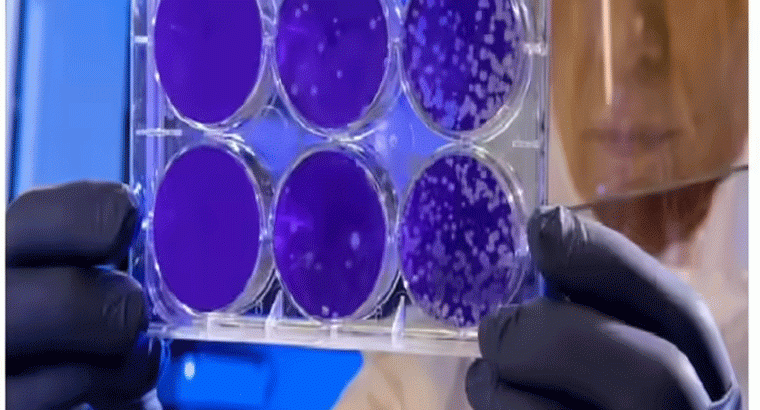

యాంటీ-బయాటిక్స్ రెసిస్టెన్స్ కేంద్రంగా భారత్.. లాన్సెట్ స్టడీ వార్నింగ్
national | Suryaa Desk | Published : Tue, Nov 18, 2025, 08:53 PM
భారత్లో యాంటీబయాటిక్ రెసిస్టెన్స్ ( సూపర్బగ్స్ ) సమస్య తీవ్రంగా ఉందని, 83% మంది భారతీయుల్లో మల్టీడ్రగ్-రెసిస్టెంట్ ఆర్గనిజమ్స్ ఉన్నాయని ఓ అధ్యయనం హెచ్చరించింది. ఏఐజీ హాస్పిటల్స్కు చెందిన పరిశోధకుల బృందం చేపట్టిన ఈ అధ్యయన ఫలితాలను లాన్సెట్ ఈ-క్లినికల్ మెడిసిన్ జర్నల్లో ప్రచురించారు. సూపర్బగ్ విస్ఫోటనానికి భారత్ మూల కేంద్రంగా ఉందని, తక్షణ విధాన మార్పులు, యాంటీబయాటిక్ స్టెవార్డ్షిప్పై జాతీయ విధానం అవసరమని అధ్యయనం నొక్కి చెప్పింది. నవంబరు 18 నుంచి 25 మధ్య యాంటీమైక్రోబయల్ స్టెవార్డ్షిప్ వారం సందర్భంగా ఈ ఫలితాలు వెలువరించారు. యాంటీబయాటిక్ వాడకాన్ని జాతీయ ప్రాధాన్యతగా మార్చాల్సిన ఆవశ్యకతను ఈ అధ్యయనం స్పష్టం చేసింది.
నాలుగు దేశాలకు చెందిన 1,200 మందికి పైగా రోగులను విశ్లేషించిన ఈ అధ్యయనం.. భారత్లో సాధారణ ఎండోస్కోపిక్ ప్రక్రియ చేయించుకున్న రోగులలో MDROల ఉనికి రేటు అత్యధికంగా ఉన్నట్టు గుర్తించింది. ఇటలీలో 31.5%, అమెరికాలో 20.1%, నెదర్లాండ్స్లో 10.8%తో పోలిస్తే భారత్లో ఈ రేటు 83%గా ఉంది. భారతీయ రోగులలో గుర్తించిన నిరోధక బ్యాక్టీరియాలో 70.2% ESBL ఉత్పత్తి చేసే జీవులు ఉన్నాయి. అంటే వీరికి సాధారణ యాంటీబయాటిక్స్ పనిచేయవు. అలాగే, యాంటీబయాటిక్స్కు నిరోధకంగా పనిచేసే కార్బపెనెమ్-రెసిస్టెంట్ బ్యాక్టీరియా 23.5% మందిలో ఉన్నట్టు తేల్చింది.
దీనిని కేవలం మెడికల్ హిస్టరీ లేదా అంతర్లీనంగా ఉన్న అనారోగ్యాలతో మాత్రమే వివరించలేమని అధ్యయనం స్పష్టం చేసింది. వయస్సు, ఇతర ఆరోగ్య సమస్యలను పరిగణనలోకి తీసుకున్నప్పటికీ ఈ తేడా ఉందని పేర్కొంది. AIG హాస్పిటల్స్ ఛైర్మన్, అధ్యయనం కో-ఆథర్ డాక్టర్ నాగేశ్వర్ రెడ్డి మాట్లాడుతూ.. ‘‘80% మందికి పైగా రోగులు ఇప్పటికే డ్రగ్-రెసిస్టెంట్ బ్యాక్టీరియాను కలిగి ఉన్నారంటే, ఈ ముప్పు ఇక ఆసుపత్రులకే పరిమితం కాదు.. ఇది మన సమాజం, పర్యావరణం, దైనందిన జీవితాలలో కూడా ఉందని అర్థం’’ అని అన్నారు.
యాంటీబయాటిక్స్ దుర్వినియోగం, ప్రిస్క్రిప్షన్ లేకుండా సులభంగా అందుబాటులో ఉండటం, చికిత్సను మధ్యలో నిలిపివేయడం, విస్తృతంగా స్వీయ-వైద్యం వంటి అంశాలతో ముడిపడిన తీవ్రమైన సామాజిక సమస్యను ఇది సూచిస్తుంది. MDROల ఉనికితో మరింత శక్తివంతమైన, విషపూరితమైన ఔషధాలను చికిత్సకు ఉపయోగించవలసి వస్తుంది. అలాగే, రోగులు కోలుకోవడానికి ఎక్కువ సమయం పడుతుంది. సమస్యలు పెరిగే ప్రమాదం ఉంది. చికిత్స ఖర్చులు కూడా గణనీయంగా పెరుగుతాయి.
ఎండీఆర్కు గురికాని (మల్టీడ్రగ్-రెసిస్టెంట్) రోగికి తీవ్రమైన ఇన్ఫెక్షన్ వస్తే, సాధారణ యాంటీబయాటిక్స్తో త్వరగా కోలుకుని, సుమారు మూడు రోజుల్లోనే డిశ్చార్జ్ అవుతారని, మొత్తం ఖర్చు రూ.70,000 వరకు అవుతుందని డాక్టర్ నాగేశ్వర రెడ్డి అన్నారు. దీనికి విరుద్ధంగా అదే సమస్యతో ఉన్న MDR రోగి సాధారణ మోతాదు యాంటీబయాటిక్స్కు స్పందించకపోతే, అధిక-స్థాయి ఔషధాలకు మారాల్సి వస్తుంది.. ఐసీయూలో చికిత్సతో పాటు 15 రోజులకు పైగా ఆసుపత్రిలో ఉండాల్సి వస్తుంది. మొత్తం ఖర్చు రూ.4-5 లక్షల వరకు ఉంటుందని ఆయన చెప్పారు.
దేశంలో ఏటా దాదాపు 58,000 నవజాత శిశు మరణాలు యాంటీబయాటిక్ ఇన్ఫెక్షన్లతో ముడిపడి ఉన్నాయని, ఐసీయూలు, కేన్సర్ కేంద్రాలలో చికిత్స చేయలేని బ్యాక్టీరియా తరచుగా ఎదురవుతుందని అధ్యయనం పేర్కొంది. ఈ అధ్యయనం ‘యాంటీమైక్రోబయల్ రెసిస్టెన్స్ (AMR) ఒక జాతీయ ఆరోగ్య అత్యవసర పరిస్థితిగా మారింది’ అనే బలమైన సాక్ష్యాన్ని అందిస్తుంది.
ప్రభుత్వాధినేతలు, ఆరోగ్య సంరక్షణ సంస్థలు దీనిని ఒక సాధారణ హెచ్చరికగా కాకుండా, తక్షణ చర్య అవసరమని బలమైన సాక్ష్యంగా పరిగణించాలని అధ్యయనకర్తలు కోరారు. ప్రిస్క్రిప్షన్కు మాత్రమే యాంటీబయాటిక్ అమ్మాలనే కఠిన విధానం ఉండాలని పిలుపునిచ్చారు. డాక్టర్ నాగేశ్వర్ రెడ్డి మాట్లాడుతూ.. దేశవ్యాప్తంగా యాంటీబయాటిక్ స్టెవార్డ్షిప్ కార్యక్రమాలు, యాంటీబయాటిక్ వినియోగం డిజిటల్ ట్రాకింగ్, బలమైన ఫార్మసీ నిబంధనలు, ప్రజలకు విస్తృత అవగాహన కల్పించేలా ప్రచారాలు ఉండాలని సూచించారు.
మానవులు, పశువులు, వ్యవసాయం, పారిశుద్ధ్యంలో యాంటీబయాటిక్ దుర్వినియోగాన్ని పరిష్కరించే సమగ్ర ‘వన్ హెల్త్’ విధానం కూడా అవసరమని ఆయన అన్నారు.
యాంటీబయాటిక్ నిరోధకత వ్యాప్తిని అడ్డుకోడానికి కచ్చితంగా పాటించాల్సిన ఆరు ముఖ్యమైన చర్యలను ఆయన సూచించారు:
1. డాక్టర్ ప్రిస్క్రిప్షన్ లేకుండా ఎప్పుడూ యాంటీబయాటిక్స్ తీసుకోవద్దు.
2. స్వొంత వైద్యం, ఫార్మసీ-ఆధారిత యాంటీబయాటిక్స్, గడువు ముగిసిన ఔషధాలను వినియోగించరాదు.
3. వైరల్ వ్యాధులకు యాంటీబయాటిక్స్ వాడొద్దు. చాలా జ్వరాలు, జలుబులు, దగ్గులకు యాంటీబయాటిక్స్ పనిచేయవని గుర్తుంచుకోవాలి.
4. డాక్టర్ సిఫార్సు చేసిన పూర్తి యాంటీబయాటిక్ కోర్సును పూర్తి చేయాలి: మధ్యలో ఆపేస్తే బ్యాక్టీరియా బలపడి నిరోధకతను పెంచుకుంటుంది.
5. బలమైన పరిశుభ్రత అలవాట్లను పాటించాలి: క్రమం తప్పకుండా చేతులు కడుక్కోవడం, శుభ్రమైన త్రాగునీరు, సురక్షితమైన ఆహార నిర్వహణ ఇన్ఫెక్షన్లను తగ్గించి తద్వారా యాంటీబయాటిక్స్ అవసరాన్ని తగ్గిస్తాయి.
6. టీకాల తీసుకోవడం: టీకాలు ఇన్ఫెక్షన్లను నివారిస్తాయి అంటే తక్కువ యాంటీబయాటిక్స్ అవసరమవుతాయి.
7. పెంపుడు జంతువులు, పశువులను బాధ్యతాయుతంగా నిర్వహించాలి: పశువైద్య సలహా లేకుండా జంతువులకు యాంటీబయాటిక్స్ ఉపయోగించవద్దు ఎందుకంటే నిరోధక బ్యాక్టీరియా జంతువులు నుంచి మానవులకు వ్యాప్తి చెందుతుంది.
తక్షణమే చర్యలు తీసుకోకుంటే సాధారణ ఇన్ఫెక్షన్లు, శస్త్రచికిత్సలు, రోజువారీ వైద్య ప్రక్రియలు ప్రాణాంతకంగా మారే ‘పోస్ట్-యాంటీబయాటిక్ యుగం’లోకి భారత్ ప్రవేశించే ప్రమాదం ఉందని అథర్లు హెచ్చరించారు. సంక్షోభం మరింత తీవ్రతరం కాకముందే, అందరూ త్వరగా చర్య తీసుకోవడానికి ఒక కీలకమైన మేల్కొలుపు అని వారు పేర్కొన్నారు.

|

|
